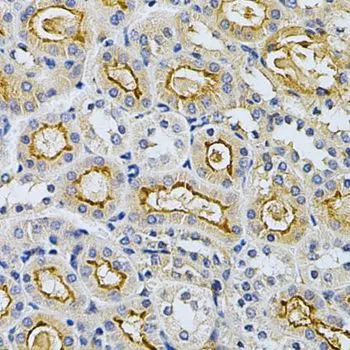
IHC-P analysis of mouse kidney tissue using GTX35230 GRK2 antibody. Dilution : 1:200 IHC-P analysis of mouse kidney tissue using GTX35230 GRK2 antibody. Dilution : 1:200

WB analysis of various sample lysates using GTX35230 GRK2 antibody. Dilution : 1:1000 Loading : 25microg per lane
GRK2 antibody
GTX35230
ApplicationsWestern Blot, ImmunoHistoChemistry, ImmunoHistoChemistry Paraffin
Product group Antibodies
TargetGRK2
Overview
- SupplierGeneTex
- Product NameGRK2 antibody - KO/KD Validated
- Delivery Days Customer9
- Application Supplier NoteWB: 1:500 - 1:2000. IHC-P: 1:50 - 1:200. *Optimal dilutions/concentrations should be determined by the researcher.Not tested in other applications.
- ApplicationsWestern Blot, ImmunoHistoChemistry, ImmunoHistoChemistry Paraffin
- CertificationResearch Use Only
- ClonalityPolyclonal
- ConjugateUnconjugated
- Gene ID156
- Target nameGRK2
- Target descriptionG protein-coupled receptor kinase 2
- Target synonymsADRBK1, BARK1, BETA-ARK1, beta-adrenergic receptor kinase 1, adrenergic beta receptor kinase 1, beta-ARK-1
- HostRabbit
- IsotypeIgG
- Protein IDP25098
- Protein NameBeta-adrenergic receptor kinase 1
- Scientific DescriptionThis gene encodes a member of the G protein-coupled receptor kinase family of proteins. The encoded protein phosphorylates the beta-adrenergic receptor as well as a wide range of other substrates including non-GPCR cell surface receptors, and cytoskeletal, mitochondrial, and transcription factor proteins. Data from rodent models supports a role for this gene in embryonic development, heart function and metabolism. Elevated expression of this gene has been observed in human patients with heart failure and Alzheimers disease. [provided by RefSeq, Sep 2017]
- Storage Instruction-20°C or -80°C,2°C to 8°C
- UNSPSC12352203

![ELISA analysis of antigen using GTX60430 GRK2 antibody [3F8]. Red : Control antigen 100ng Purple : Antigen 10ng Green : Antigen 50ng Blue : Antigen 100ng](https://www.genetex.com/upload/website/prouct_img/normal/GTX60430/GTX60430_20170912_ELISA_w_23061123_556.webp)


